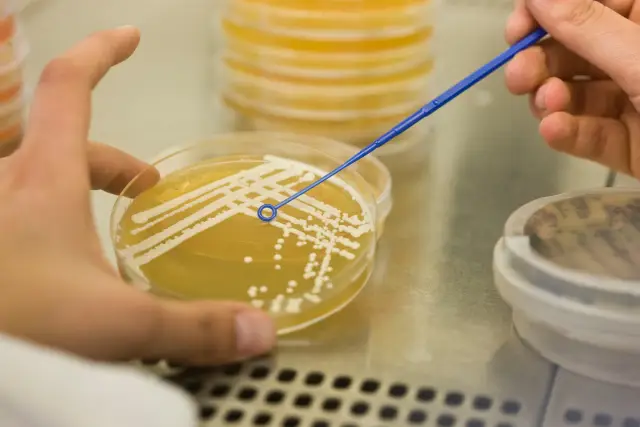
Синтетические микроорганизмы позволяют ученым изучать древние тайны эволюции: ученые используют инструменты синтетической биологии для создания организмов, подобных тем, которые, как считается, жили м

Ученые из Scripps Research и их сотрудники создали микроорганизмы, которые могут воспроизводить ключевые черты организмов, которые, как считается, жили миллиарды лет назад, что позволяет им исследовать вопросы о том, как жизнь эволюционировала от неодушевленных молекул к одноклеточным организмам и сложные, многоклеточные формы жизни, которые мы видим сегодня.
Изучая один из этих искусственных организмов - бактерию, чей геном состоит как из рибонуклеиновой кислоты (РНК), так и из дезоксирибонуклеиновой кислоты (ДНК), - ученые надеются пролить свет на раннюю эволюцию генетического материала, включая теоретический переход из мира, где большая часть жизни зависела исключительно от генетической молекулы РНК, в мир, где ДНК служит основным хранилищем генетической информации.
Используя второй сконструированный организм, генетически модифицированные дрожжи, содержащие эндосимбиотическую бактерию, они надеются лучше понять происхождение клеточных электростанций, называемых митохондриями. Митохондрии обеспечивают жизненно важную энергию для клеток эукариот, обширной группы организмов, включая людей, обладающих сложными клетками, содержащими ядро.
Исследователи сообщают об инженерии микробов в двух статьях, одна из которых опубликована 29 октября 2018 года в Proceedings of the National Academy of Sciences (PNAS), а другая опубликована 30 августа 2018 года в Journal of the American Chemical Society (JACS)..
«Эти искусственные организмы позволят нам исследовать две ключевые теории об основных вехах в эволюции живых организмов - переходе от мира РНК к миру ДНК и переходе от прокариот к эукариотам с митохондриями», - говорит Питер. Шульц, доктор философии, старший автор статей и президент Scripps Research. «Доступ к легко управляемым лабораторным моделям позволяет нам искать ответы на вопросы о ранней эволюции, которые раньше казались неразрешимыми».
Происхождение жизни на Земле интересовало человечество на протяжении тысячелетий. Ученые проследили развитие жизни на несколько миллиардов лет назад и пришли к выводу, что простейшие формы жизни возникли из первичного химического бульона Земли и впоследствии эволюционировали в течение тысячелетий в организмы все большей и большей сложности. Грандиозный скачок произошел с появлением ДНК, молекулы, которая хранит всю информацию, необходимую для репликации жизни, и направляет клеточный механизм выполнять свои приказы, прежде всего путем создания РНК, которая, в свою очередь, управляет синтезом белков, молекулярных рабочих лошадок в клетках.
В 1960-х годах Карл Вёзе и Лесли Оргел вместе с пионером в области ДНК Фрэнсисом Криком предположили, что до ДНК организмы полагались на РНК для переноса генетической информации, молекулы, похожей на ДНК, но гораздо менее стабильной, которая также может катализируют химические реакции подобно белкам. «На уроках естественных наук студенты узнают, что ДНК ведет к РНК, которая, в свою очередь, ведет к белкам - это центральная догма биологии, - но гипотеза мира РНК переворачивает все с ног на голову», - говорит Ангад Мехта, доктор философии, первый автор новых статей. и научный сотрудник с докторской степенью в Scripps Research. «Чтобы гипотеза мира РНК оказалась верной, нужно каким-то образом перейти от РНК к геному ДНК, однако, как это могло произойти, до сих пор остается большим вопросом среди ученых».
Одна из возможностей заключается в том, что переход происходил через своего рода микробное недостающее звено, реплицирующийся организм, который хранил генетическую информацию в виде РНК. Для исследования JACS группа под руководством Scripps Research создала бактерии Escherichia coli, которые частично строят свою ДНК с помощью рибонуклеотидов, молекулярных строительных блоков, обычно используемых для построения РНК. Эти сконструированные геномы содержали до 50 процентов РНК, таким образом, одновременно представляя новый тип синтетического организма и, возможно, возвращение на миллиарды лет назад..
Мехта предупреждает, что их работа до сих пор была сосредоточена на характеристике этого химерного генома РНК-ДНК и его влияния на рост и репликацию бактерий, но явно не исследовала вопросы перехода от мира РНК к миру ДНК. Но, по его словам, тот факт, что E. coli, половина генома которой состоит из РНК, может выживать и размножаться, примечателен и, по-видимому, подтверждает возможность существования эволюционно переходных организмов, обладающих гибридными геномами РНК-ДНК. Исследовательская группа Scripps в настоящее время изучает, как функционируют смешанные геномы сконструированной ими кишечной палочки, и планирует использовать бактерии для изучения ряда эволюционных вопросов.
Например, один из вопросов заключается в том, приводит ли присутствие РНК к быстрому генетическому дрейфу - значительным изменениям в последовательности генов в популяции с течением времени. Ученые предполагают, что массивный генетический дрейф произошел быстро на ранней стадии эволюции, и присутствие в геноме РНК может помочь объяснить, почему генетические изменения произошли так быстро.
В статье, опубликованной в PNAS, исследователи сообщают о разработке еще одной лабораторной модели эволюционной вехи, которая, как считается, произошла более 1,5 миллиарда лет назад. Они создали дрожжи, зависящие от энергии бактерий, живущих внутри них, в качестве полезного паразита или «эндосимбионта». Этот составной организм позволит им исследовать древнее происхождение митохондрий - крошечных бактериоподобных органелл, которые производят химическую энергию в клетках всех высших организмов.
Митохондрии, по общему мнению, произошли от обычных бактерий, которые были захвачены более крупными одноклеточными организмами. Они выполняют несколько ключевых функций в клетках. Самое главное, они служат кислородными реакторами, используя O2 для создания основной единицы химической энергии клеток, молекулы АТФ. Какими бы важными ни были митохондрии для клеток, их происхождение остается несколько загадочным, хотя есть явные намеки на то, что они произошли от более независимого организма, который, по широко распространенному мнению, был бактерией.
Митохондрии имеют двойную мембранную структуру, как у некоторых бактерий, и, опять же, как и бактерии, содержат собственную ДНК. Анализ митохондриального генома позволяет предположить, что он имеет общего древнего предка с современными бактериями Rickettsia, которые могут жить в клетках своих хозяев и вызывать заболевания. Более сильное подтверждение бактериального происхождения теории митохондрий можно было бы получить из экспериментов, показывающих, что независимые бактерии действительно могут быть преобразованы в ходе эволюции, подобной митохондриям, в симбионтов, подобных митохондриям. С этой целью ученые Scripps Research разработали бактерии E. coli, которые могут жить в клетках Saccharomyces cerevisiae, также известных как пекарские дрожжи, зависеть от них и оказывать ключевую помощь им.
Исследователи начали с модификации E.coli, в котором отсутствует ген, кодирующий тиамин, что делает бактерии зависимыми от дрожжевых клеток для получения этого важного витамина. В то же время они добавили к бактериям ген транслоказы АДФ/АТФ, белка-переносчика, чтобы АТФ, вырабатываемый в бактериальных клетках, поставлялся их дрожжевым клеткам-хозяевам, имитируя центральную функцию настоящих митохондрий. Команда также модифицировала дрожжи, чтобы их собственные митохондрии были дефицитны в снабжении АТФ. Таким образом, нормальное производство АТФ на основе митохондрий будет зависеть от бактерий.
Команда обнаружила, что некоторые из сконструированных бактерий после модификации поверхностными белками, чтобы защитить их от уничтожения дрожжами, жили и размножались в гармонии со своими хозяевами более 40 поколений и оказались жизнеспособными на неопределенный срок.. «Похоже, модифицированные бактерии накапливают новые мутации внутри дрожжей, чтобы лучше адаптироваться к новому окружению», - говорит Шульц.
Установив эту систему, команда попытается развить E.coli превращаются в митохондриоподобные органеллы. Для нового эндосимбионта E. coli адаптация к жизни внутри дрожжей может дать ему возможность радикально уменьшить свой геном. Типичная бактерия E. coli, например, имеет несколько тысяч генов, тогда как митохондрии развили урезанный набор всего из 37.
Исследовательская группа Scripps завершила исследование дальнейшими экспериментами по вычитанию генов, и результаты были многообещающими: они обнаружили, что могут устранить не только ген тиамина E. coli, но и гены, лежащие в основе производства метаболической молекулы. НАД и аминокислота серин, и все равно получится жизнеспособный симбиоз.
«Сейчас мы находимся на пути к тому, чтобы показать, что мы можем удалить гены, отвечающие за производство всех 20 аминокислот, которые составляют значительную часть генома кишечной палочки», - говорит Шульц. «Как только мы этого добьемся, мы перейдем к удалению генов синтеза кофакторов и нуклеотидов, и в течение нескольких лет мы надеемся получить действительно минимальный эндосимбиотический геном."
Исследователи также надеются использовать аналогичные системы эндосимбионт-хозяин для изучения других важных эпизодов эволюции, таких как происхождение хлоропластов, светопоглощающих органелл, которые играют митохондриальную роль в обеспечении растений энергией.